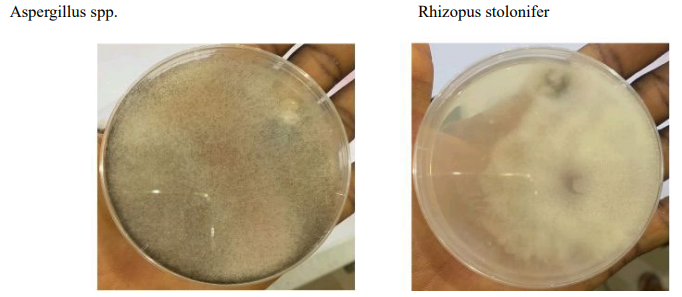
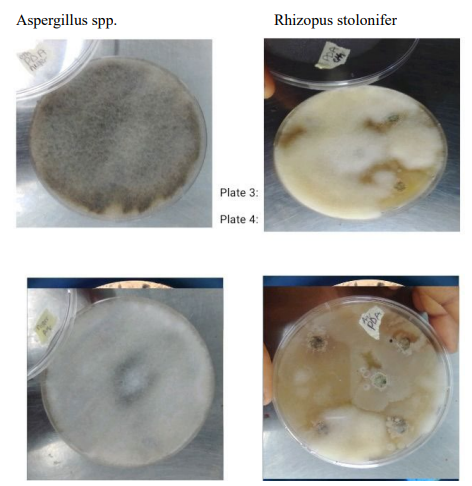

Research Article - (2024) Volume 3, Issue 2
Biocontrol Potential of Ocimum Gratissimum on Some Fungal Isolates from Arachias Hypogea
2Biocrops Biotechnology Company Limited, Abuja, Nigeria
3Sheda Science and Technology Complex, P.M.B 186, Garki, Abuja, Nigeria
Received Date: Jan 20, 2024 / Accepted Date: Feb 20, 2024 / Published Date: Mar 12, 2024
Copyright: ©Â©2024 J.C. Ogbu, et al. This is an open-access article distributed under the terms of the Creative Commons Attribution License, which permits unrestricted use, distribution, and reproduction in any medium, provided the original author and source are credited.
Citation: Ogbu, J. C., Nwosu, P. C., Okwute, L. O., Anucha, C. J., Abubakar, S. (2024). Biocontrol Potential of Ocimum Gratissimum on Some Fungal Isolates from Arachias Hypogea. Archives Clin Med Microbiol, 3(2), 01-04.
Abstract
Isolation of fungi was carried out from groundnut (arachais hypogae) seeds, and two fungi was isolated, Aspergillus spp and Rhizopus stolonifer. Proximate analysis of Ocimum gratissimum was carried out with moisture content of 9.32 , ash content of 10.90, nitrogen content of 3.78 and protein content of 22.03. Aqueous and Ethanolic extract of scent leaf ( Ocimum Gratissimum) was obtained and tested on the fungi isolates and Rhizopus stolonifer associated with groundnut was inhibited by aqueous and Ethanolic extracts of Ocimum Gratissimum while both aqueous and Ethanolic extracts of the plant did not show any activity against Aspergillus Niger associated with groundnut.
Introduction
To protect food and feedstuffs there are several possible control strategies employed in peanut such as treating peanuts with fungicides, fumigants, or biocontrol agents [1]. stated that groundnut is highly susceptible to mycoflora diseases as they are rich in nutrients, such fungi include; Rhizopus spp., Penicillium spp., Aspergilllus niger and Aspergillus flavus [2]. These fungi cause several diseases such as seed rot, necrosis, leaf spot, rust, crown rot, damping off, wilt, grey mold, black mold etc., and the end result of these infections is a severe qualitative and quantitative yield loss. The susceptibility of groundnut seeds to fungal pathogens is usually enhanced by poor methods of processing and storage of the seeds, which often lead to the release of toxins that are carcinogenic and when consumed by humans and animals cause lungs/liver cancer as well as other cardiovascular diseases. Groundnut pods are continuously dried till moisture level is reduced below 10% to avoid contamination and also preserves seed viability. Ocimum Gratissimum is an herbaceous plant which belongs to the Labiatae family. The plant is indigenous to tropical areas especially India and it is also in West Africa. In Nigeria, it is found in the Savannah and coastal areas. It is cultivated in Ceylon, South Sea Islands, and also within Nepal, Bengal, Chittagong and Deccan. It is known by various names in different parts of the world. In India it is known by its several vernacular names, the most commonly used ones being Vriddhutulsi (Sanskrit), Ram tulsi (Hindi), Nimma tulasi (Kannada). In the southern part of Nigeria, the plant is called “effinrin-nla” by the Yoruba speaking tribe. It is called “Ahuji” by the Igbos, while in the Northern part of Nigeria, the Hausas call it “Daidoya” [3].
Materials and Methods
Study Area
This study was carried out at the laboratory of the Department of Microbiology at the University of Abuja.
Collection of Materials
Groundnut seeds were purchased from Gwagwalada market. Seed sorting was done manually by hand to separate wholesome from unwholesome seeds following the procedure of [4].
Media Preparation
Potato Dextrose Agar was used in this research to isolate and identify the fungi; and the media was prepared according to manufacturer’s instruction 3.9g of Potato Dextrose Agar was weighed and dissolved into 100ml of distilled water in a conical flask. Cotton wool was then placed to cover it and wrapped with Aluminium foil. After which the solution was then autoclaved at 121â?? for 15 minutes, it was then allowed to cool and dispensed into Petri-dishes. 1ml of the sample was dropped into 9ml of normal saline and shake vigorously to form a uniform solution of 10-1 concentration. The stock was subjected to a decimal dilution to form 10-2, 10-3, 10-4, 10-5 and 10-6 concentration [5].
Inoculation and Incubation
1ml pipette was employed to drop 0.01ml of the inoculums into the Petri-dishes and evenly spread all over the surface of the agar plate using stirring rod. All plates were incubated immediately after inoculation and placed upside down to prevent drops of condensations from collecting on the inoculated surface. Potato Dextrose Agar plates were incubated for 28â?? for 48hrs, after which pure culture was prepared from the distinct fungal isolate observed [5].
Characterization and Identification of Isolates
The fungal growth observed in the pure culture was identified as described by CMI (2010). Identification was done microscopically and macroscopically. Colony characteristics such as appearance, change in medium colour and growth rate were observed. Shape of the conidia and conidiophores were taken note of. These features were matched with standards.
Collection of Plant Material
Fresh leaves of scent leaf (Ocimum gratissimum) were collected in polythene bags and transported to the Microbiology laboratory of the University of Abuja for preparation of the extract.
Proximate Analysis of Ocimum gratissimum
The proximate analysis was carried out at the chemistry laboratory of Sheda Science and Technology Complex using standard methods.
Preparation of Extracts
Aqueous and ethanolic extracts of Ocimum gratissimum was prepared. The leaves were washed under running tap water and soaked in 1% of sodium hypochloride chloride for 30 seconds. They were rinsed in sterile distilled water and air dried at room temperature. 350g each of the leaves of Ocimum gratissimum was weighed for aqueous and ethanolic extraction. The leaves were ground using mortar and pestle after which the macerate was transferred into two beakers containing 1000ml of sterile distilled water and 1000ml of ethanol which was filtered after 24hours and extract collected.
Concentration of Crude Extracts
Serial dilutions of the crude extract were prepared to give different concentrations of 60g/ml, 70g/ml, 80g/ml, 90g/ml and 100g/ml.
Antifungal Sensitivity Test
Antifungal susceptibility test was performed on the fungal isolate using antibiotic discs impregnated with the different concentrations of the extracts. The different concentrations of extracts in discs were placed equidistant from each other on sterile solidified PDA plate containing the fungal isolate and incubated for 24hrs and the zone of inhibition obtained afterwards was measured.
Results
|
Isolates |
Morphological characteristics |
Microscopic Appearance |
Probable Organism |
|
1 |
Initial growth is white, later becoming black with pale yellow on the reverse side |
Errect conidiophores and hyphae is septate |
Aspergillus spp |
|
2 |
Brownish grey color, colony fast growing with whitish margin |
Short rhizoids, sporangiophore unbranched and hyphae is coenocytic |
Rhizopus stolonifer |
Table 1. Identified Fungi with their Morphological Characteristics
Figure: Morphological Characteristics of Fungal Isolate
|
Extract Conc (%) |
Ethanolic Extract |
Aqueous Extract |
||
|
Aspergillus niger |
Rhizopus stolonifer |
Aspergillus niger |
Rhizopus stolonifer |
|
|
60 |
- |
+ |
- |
- |
|
70 |
- |
+ |
- |
- |
|
80 |
- |
- |
- |
+ |
|
90 |
- |
- |
- |
+ |
|
100 |
- |
- |
- |
+ |
Table showing the fungicidal activity of Ocimum gratissimum
Picture showing Fungicidal activity of the Ethanolic and aqueous plant extracts on the test fungi.
Percentage composition (%) of Ocimum gratissimum
|
Parameter |
Composition |
|
Moisture |
9.32 |
|
Nitrogen |
3.78 |
|
Protein |
22.03 |
|
Ash |
10.90 |
Means (p≤0.05)
Table 3. Proximate composition of Ocimum gratissimum
Discussion
Fungi had been known to affect groundnut production for a long time. Two fungal species were identified in this research: Aspergillus niger and Rhizopus stolonifer. These fungi were among the microorganisms isolated from previous findings; Fagbohun and Faleye isolated Aspergillus niger, Aspergillus flavus, Rhizopus spp [6]. Mucor spp. and Aspergillus fumigatus in sundried groundnut, Adebesin et al., isolated Aspergillus flavus, Aspergillus niger, Aspergillus tamarii, Penicillium Citrinum, Rhizopus stolonifer and Macrophomina phaseolina in roasted groundnut sold in Bauchi State, Ibrahim (2014) observed Mucor spp., Aspergillus spp., Penicillium spp., Curvularia spp., Fusarium spp. and Rhizopus spp. in groundnut seeds sold in Aliero central market, Ekiti state [7]. Also, Aspergillus spp., Penicillium spp., Fusarium spp., Mucor spp. and Rhizopus spp. were isolated from unpeeled groundnut sold in Yenagoa metropolis [8]. Akinnibosun and Osawaru isolated Neurospora spp., Aspergillus niger, Aspergillus flavus, Mucor spp. Rhizopus spp., Penicillium spp., Trichoderma spp. and Fusarium spp. in peeled and unpeeled groundnut seeds sold in Benin City [9]. The fungi isolated in this research are toxin producing organisms and they cause series of health challenges ranging from vomiting to cancer of major organs and sometimes death [10]. The fungi associated with groundnut in this study were Aspergillus niger and Rhizopus stolonifer. Aspergillus niger showed the highest occurrence while Rhizopus stolonifer was the least. The fungal Organisms must have been present right from the field, and after harvest transferred to storage houses and market places. Few data are available on the in vitro susceptibility profile of Rhizopus spp.
The proximate composition of ocimum gratissimum presented in Table 3 showed the moisture 9.32%,nitrogen 3.78%,protein 22.03%, Ash 10.90%. The aqueous and ethanolic extracts of Ocimum gratissimum inhibited the growth of Rhizopus stolonifer tested. The highest percentage inhibition of mycelia growth of the Rhizopus stolonifer was recorded at 90% followed by 80% and 100% aqueous extract concentration of Ocimum gratissimum. , while the ethanolic extract of Ocimum gratissimum showed inhibition at 70% and 60% concentration in Rhizopus stolonifer, the least antifungal activity was recorded in 60% ethanolic extract of Ocimum gratissimum the Rhizopus stolonifer. Both aqueous and ethanolic extract of Ocimum gratissimum did not show any inhibition against Aspergillus niger. These results agreed with earlier works on the inhibitory action of plant products employed on the mycelia and spore germination of other pathogenic fungi [11]. This study corroborates the report of other workers, that Ocimum gratissimum is among important plants whose extracts are capable of checking the spread of many fungal diseases of food crops [12].
Conclusion
This study has shown that Rhizopus stolonifer associated with groundnut was inhibited by the aqueous and ethanolic extracts of Ocimum gratissimum while both aqueous and ethanolic extract of the plant did not show any activity against Aspergillus niger associated with groundnut at all the concentrations in vitro.
Recommendation
The fungicidal attribute evidenced in this study can further be developed pharmacologically for the control of pathogenic fungi in groundnut and other microbial agents of other crop diseases.
References
- Kong, Q., Shan, S., Liu, Q., Wang, X., & Yu, F. (2010).Biocontrol of Aspergillus flavus on peanut kernels by use of a strain of marine Bacillus megaterium. International Journal of Food Microbiology, 139(1-2), 31-35.
- Subrahmanyam, P., Wongkaew, S., Reddy, D. V. R., Demski,J. W., McDonald, D., Sharma, S. B., & Smith, D. H. (1992). Field diagnosis of groundnut diseases. International Crops Research Institute for the Semi-Arid Tropics.
- Effraim, K. D., Jacks, T. W., & Sadipo, O. A. (2003). Histopathological studies on the toxicity of Ocimum gratissimumleave extract on some organs of rabbit. African Journal of Biomedical Research, 6(1).
- Kawube, G., Kanobe, C., Edema, R., Tusiime, G., Mudingotto,P. J., & Adipala, E. (2005). Efficacy of manual seed sorting methods in reduction of transmission of rice and cowpea seed-borne diseases. In African Crop Science Conference Proceedings (Vol. 7, No. pt. 03 of 03, pp. 1363-1367).
- Harrigan, W. F. (1998). Laboratory methods in food microbiology 3rd ed. Academic Pres, London, UK.
- Faleye, O. S., & Fagbohun, E. D. (2012). Effects of storage on the proximate, mineral composition and mycoflora of “Tinco” dried meat sold in oshodi market, lagos state, Nigeria. Global J. of Bio-Science and Biotechnology, 1(1), 54-58.
- Adebesin, A. A., Saromi, O. T., Amusa, N. A., & Fagade, S. O. (2001). Microbiological quality of some groundnut products hawked in Bauchi, a Nigerian City. Journal of food technology in Africa, 6(2), 53-55.
- Kigigha, L. T., Igoya, U. O., & Izah, S. C. (2016). Microbiological quality assessment of unpeeled groundnut sold in yenagoa metropolis, Nigeria. International Journal of Innovative Biochemistry & Microbiology Research, 4(4), 11-22.
- Akinnibosun, F. I., & Osawaru, E. E. (2015). Quality assessment of peeled and unpeeled roasted groundnut (Arachis hypogaea L.) Sold in Benin City, Nigeria. International Research Journal of Natural and Applied Sciences, 2(3), 18-32.
- Akinyemi, A. A., Adejola, A. Q., Obasa, S. O., & Ezeri, G. N.O. (2012). Aflatoxins in smoked-dried fish sold in Abeokuta, Ogun State, South-west Nigeria. COLERM Proceedings, 2, 478-487.
- Ajayi, A. M., & Olufolaji, D. B. (2008). The Biofungicidal Attributes of some plant extracts on Colletotrichum capsici; the fungal pathogen of brown blotch disease of cowpea. Nigerian Journal of mycology, 1(1), 59-65.
- Okoi, A. I., & Afuo, C. O. (2009). Effect of leaf extracts of three plant species on Cercospora arachidicola Hori, the causal fungus of leaf spot disease of groundnut (Arachis hypogea L) Nig. Jour. Plt. Protect, 22, 132-139.



